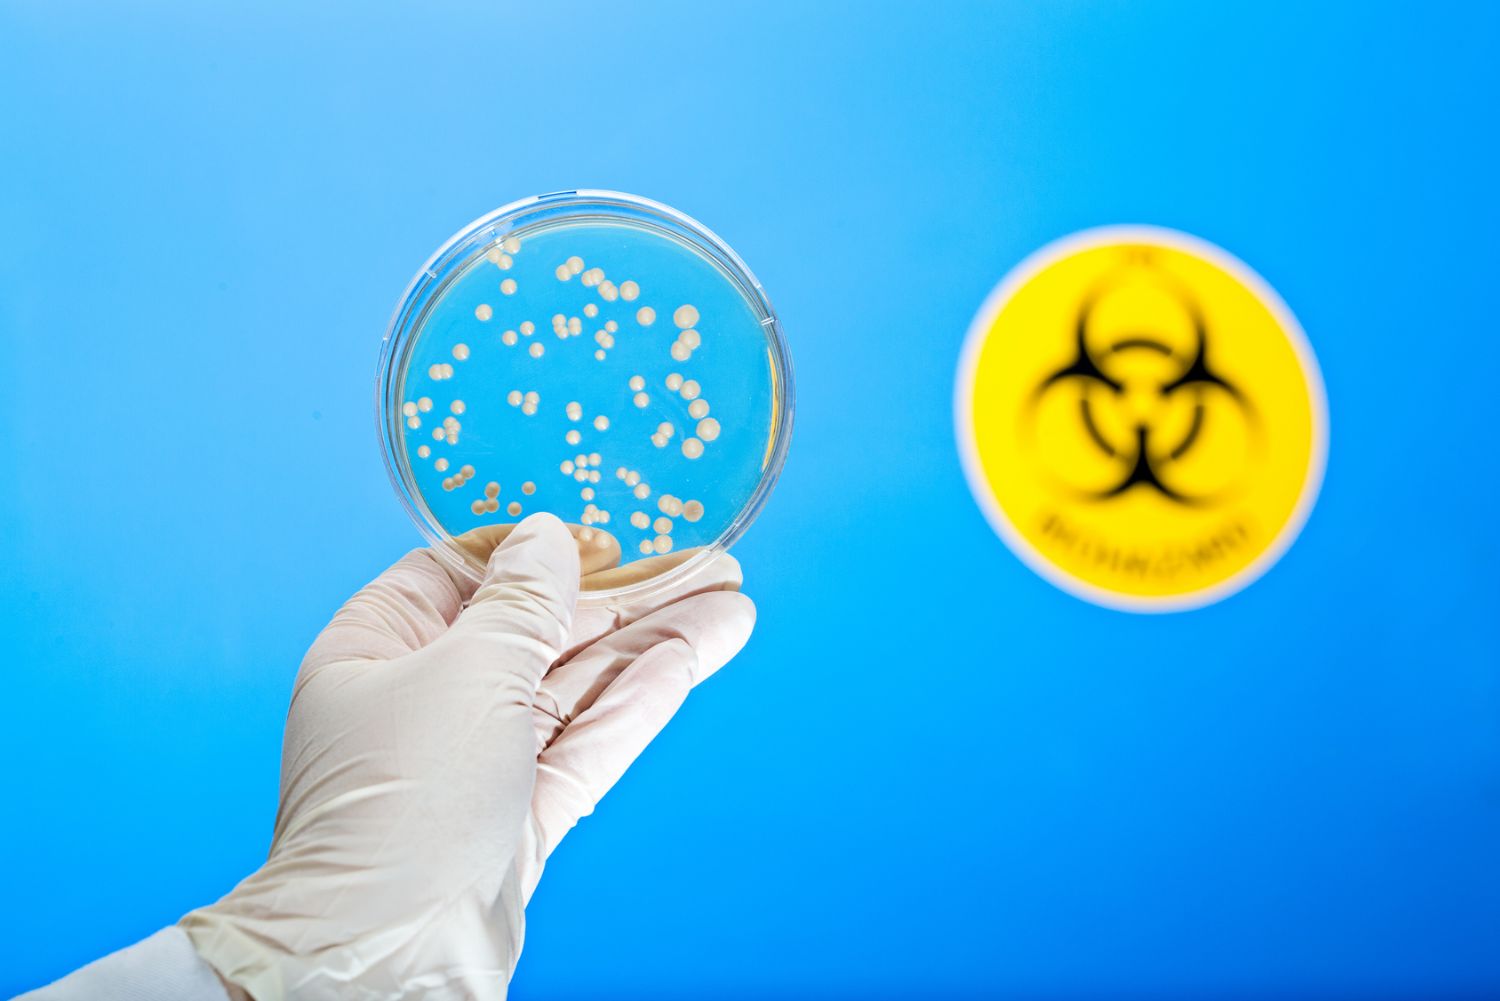
Valutazione Rischio Biologico: Prevenzione, gestione e importanza

Il datore di lavoro ha il compito di effettuare la valutazione del rischio per la salute dei lavoratori dovuta ad agenti biologici deliberatamente o occasionalmente presenti nell'ambiente lavorativo.
Per valutare l'entità del rischio da esposizione, nel processo di valutazione è necessario:
- Identificare pericoli potenziali e reali;
- Stimare la gravità delle conseguenze;
- Identificare e quantificare i soggetti esposti;
- Misurare l'entità di tale esposizione.
La valutazione del Rischio Biologico presenta tuttavia aspetti di incertezza notevoli, legati principalmente alla grande varietà di agenti da valutare, molti dei quali caratterizzati da complesse interazioni specifiche ed ambientali che possono favorirne o limitarne la proliferazione, e alla diversa risposta di ciascun individuo all'esposizione.
La valutazione del rischio deve tenere conto di tutti i lavoratori anche quelli temporaneamente o stabilmente più sensibili, ad esempio soggetti autoimmuni o le donne in gravidanza.
Delle specifiche utili in fase di analisi sono:
- Modalità di interazione microrganismo-ospite;
- Il ciclo complessivo dell’infezione;
- Fattori in grado di aumentare la patogenicità.
Tali informazioni, però, non sempre sono disponibili; la stima dell'esposizione, per esempio, valutabile attraverso la misura della contaminazione ambientale, presenta notevoli aspetti di incertezza: mancano metodiche di monitoraggio standardizzate, i dati sono spesso dispersi e non esistono valori limite di esposizione affidabili e definiti.

Inoltre, per la maggior parte degli agenti biologici non sono note le relazioni dose - effetto e dunque non si possono "definire" dosi utilizzabili come valori limite di esposizione.
In realtà però, è che non esiste una soglia di infettività, cioè è sufficiente anche un solo microrganismo a provocare l'infezione (Dose Minima Infettante, DI0 = 1) e, quando questa condizione è abbinata ad una elevata patogenicità, trasmissibilità e limitata neutralizzabilità, l'unico intervento efficace per la prevenzione del rischio risulta l'eliminazione dell'esposizione.
Al termine del processo di valutazione del rischio il datore di lavoro è tenuto a predisporre gli interventi necessari alla riduzione, o eliminazione laddove possibile, dell'esposizione agli agenti biologici pericolosi e ad adottare le misure di prevenzione e protezione più idonee, commisurate all'entità del rischio.